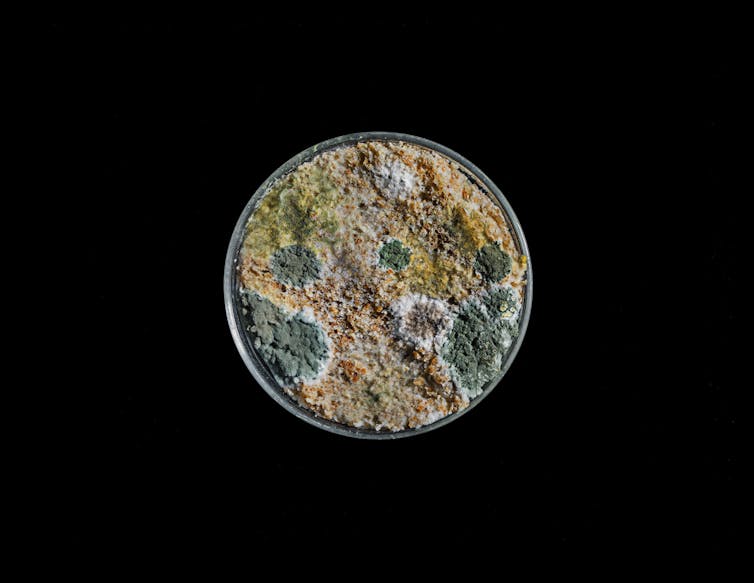

Should I worry about mold growing in my home?
Mold growth happens in damp indoor areas and is difficult to prevent. It can be an annoyance but usually isn’t harmful to your health.

Mold growth in your home can be unsettling. Blackened spots and dusty patches on the walls are signs that something is amiss, but it is important to distinguish between mold growth that is a nuisance and mold growth that may be harmful.
There are more than 1 million species of fungi. Some are used to produce important medications. Others can cause life-threatening infections when they grow in the body.
Microscopic fungi that grow in homes are a problem because they can trigger asthma and other allergies. In my work as a fungal biologist, however, I have yet to encounter robust scientific evidence to support claims that indoor molds are responsible for other serious illnesses.
What are molds?
Molds are microscopic fungi that grow on everything. This may sound like an exaggeration, but pick any material and a mold will be there, from the leaves on your houseplant to the grain in your pantry and every pinch of soil on the ground. They form splotches on the outside of buildings, grow in crevices on concrete paths and roads, and even live peacefully on our bodies.
Molds are important players in life on Earth. They’re great recyclers that fertilize the planet with fresh nutrients as they rot organic materials. Mildew is another word for mold.
Fungi, including molds, produce microscopic, seed-like particles called spores that spread in the air. Mold spores are produced on stalks. There are so many of these spores that you inhale them with every breath. Thousands could fit within the period at the end of this sentence.
When these spores land on surfaces, they germinate to form threads that elongate, and they branch to create spidery colonies that expand into circular patches. After mold colonies have grown for a few days, they start producing a new generation of spores.
Where do indoor molds grow?
Molds can grow in any building. Even in the cleanest homes, there will be traces of mold growth beneath bathroom and kitchen sinks. They’re also likely to grow on shower curtains, as well as in sink drains, dishwashers and washing machines.
Molds grow wherever water collects, but they become a problem in buildings only when there is a persistent plumbing leak, or in flooded homes.

There are many species of indoor molds, which an expert can identify by looking at their spores with a microscope.
The types of molds that grow in homes include species of Aspergillus and Penicillium, which are difficult to tell apart. These are joined by Cladosporium and Chaetomium, which loves to grow on wet carpets.
Stachybotrys is another common fungus in homes. I’ve found it under plant pots in my living room.
When does mold growth become a problem?
Problematic mold growth occurs when drywall becomes soaked through and mold colonies develop into large, brown or black patches. If the damaged area is smaller than a pizza box, you can probably clean it yourself. But more extensive mold growth often requires removing and replacing the drywall. Either way, solving the plumbing leak or protecting the home from flooding is essential to prevent the mold from returning.

In cases of severe mold growth, you can hire an indoor air quality specialist to measure the concentration of airborne spores in the home. Low concentrations of spores are normal and present no hazard, but high concentrations of spores can cause allergies.
During air testing, a specialist will sample the air inside and outside the home on the same day. If the level of spores measured in indoor air is much higher than the level measured in the outdoor air, molds are likely growing somewhere inside the home.
Another indication of mold growth inside the home is the presence of different kinds of molds in the outdoor and indoor air. Professional air sampling will identify both of these issues.
Why are indoor molds a problem?
Indoor molds present three problems. First, they create an unappealing living space by discoloring surfaces and creating unpleasant, moldy smells. Second, their spores, which float in the air, can cause asthma and allergic rhinitis, or hay fever.
Finally, some molds produce poisonous chemicals called mycotoxins. There is no scientific evidence linking mycotoxins produced by indoor molds to illnesses among homeowners. But mycotoxins could cause problems in the most severe cases of mold damage – usually in flooded homes. Irrespective of mycotoxin problems, you should treat mold growth in these more severe situations to prevent allergies.

The mold called Stachybotrys has been called the toxic black mold since its growth was linked to lung bleeding in infants in Cleveland in the 1990s. This fungus grows on drywall when it becomes soaked with water and produces a range of mycotoxins.
Black mold spores are sticky and are not blown into the air very easily. This behavior limits the number of spores that anyone around will likely inhale, and it means that any dose of the toxins you might absorb from indoor mold is vanishingly small. But the developing lungs of babies and children are particularly vulnerable to damage. This is why it is important to limit mold growth in homes and address the sources of moisture that stimulate its development.
Knowing when indoor molds require attention is a useful skill for every homeowner and can allow them to avoid unnecessary stress.
Nicholas Money does not work for, consult, own shares in or receive funding from any company or organization that would benefit from this article, and has disclosed no relevant affiliations beyond their academic appointment.
Read These Next
Gun trafficking from the US to Mexico: The drug connection
Some of the same people caught illegally trafficking firearms across the border to Mexico are also selling…
US gun trafficking to Mexico: Independent gun shops supply the most dangerous weapons
Independent gun dealers supplied 83% of crime guns seized in Mexico and traced back to purchases in…
Like many populist leaders, Trump accuses judges of being illegitimate obstacles to safety and democ
Political leaders in El Salvador, the Philippines and Israel, among other places, have also positioned…